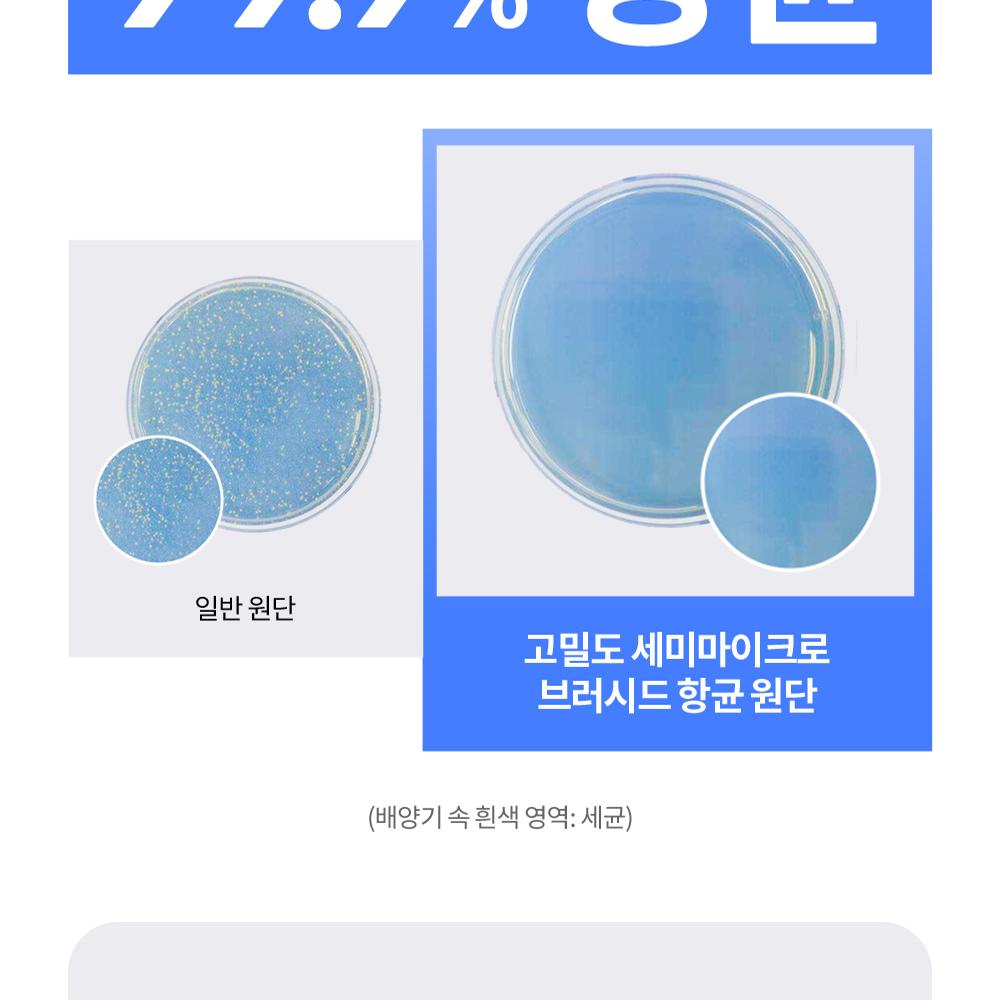

Notices
• Delivery will be completed within an average of 3-5 business days from the date of payment and shipping information completion (excluding weekends and public holidays in Korea).
The delivery time may be extended if there is a high volume of orders.• If the delivered product is defective or incorrect, please contact the SodaGift Support Team (support@sodagift.com) within 7 days of delivery for a refund or exchange.

 Delivery
Delivery